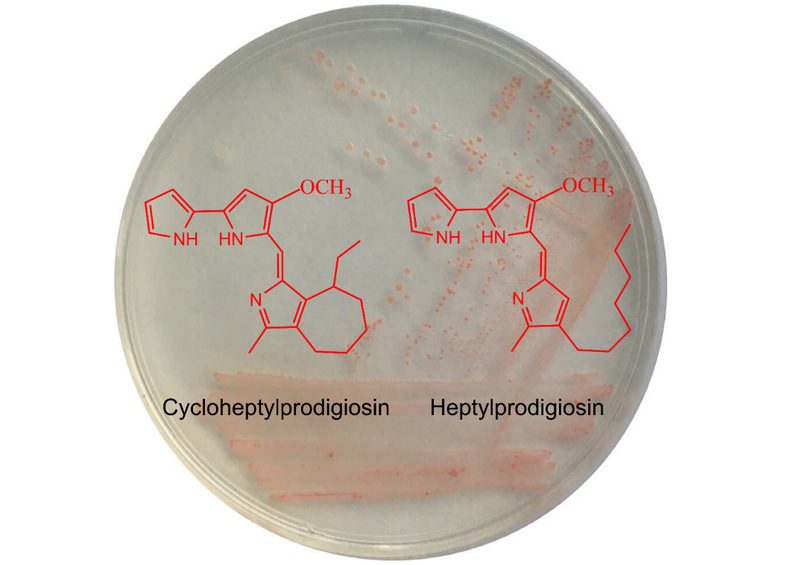

成果名称:灵菌红素产生菌及灵菌红素新化合物研究
研发人员:董乐、黄兆斌、林晓思
所属领域:海洋微生物学
完成单位:威尼斯9499登录入口
项目简介:
灵菌红素(prodigiosin)是微生物产生的一类红色素,其结构中具有三个吡咯环。灵菌红素在抗菌、抗肿瘤、免疫抑制、抗病毒、纺织染料等方面都具有重要生物活性及应用前景。
本研究从泉州湾近岸互花米草生长区沉积物中分离到一株新的产生灵菌红素菌株S2-4-1HT (= MCCC 1K03745T = KCTC 72148T),命名为红色邻米草菌(Spartinivicinus ruber)。经过菌株培养、化合物提取、分离、质谱及核磁谱解析结构,该菌株同时产生两种灵菌红素,分别鉴定为庚基灵菌红素(heptylprodigiosin,分子式C22H29N3O)与环庚基灵菌红素(cycloheptylprodigiosin,分子式C22H27N3O)(图1)。通过抑菌实验表明,这两种灵菌红素均具有较好的抑菌效果,并且环庚基灵菌红素具有更好的抑菌效果。初步实验显示,这种新的灵菌红素的活性在抗肿瘤、抗菌、溶藻效果高于其他已知灵菌红素。